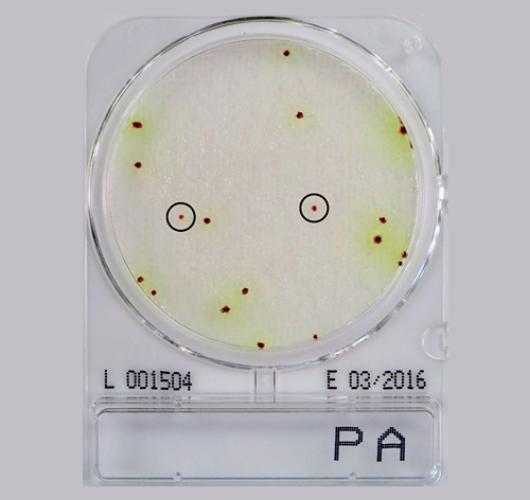
Подложки синегнойная палочка - Compact Dry PА

Подложки синегнойная палочка - Compact Dry PА
Подложки синегнойная палочка - Compact Dry PА
Готовая к использованию сухая хромогенная среда для идентификации Синегнойная палочка (Pseudomonas Aeruginosa).
Синегнойная палочка (Pseudomonas Aeruginosa) является психротрофной бактерией и может размножаться при низких температурах, вызывая порчу охлажденных пищевых продуктов, таких как мясо, птица, рыба, молоко и молочные продукты.
Его можно найти повсюду, и он хорошо себя чувствует в почве, пресной воде и морской среде. Помимо продуктов питания, его также можно обнаружить в клинических условиях и косметических/фармацевтических продуктах.
Pseudomonas aeruginosa является патогеном и распространенной проблемой пищевой и фармацевтической промышленности.
На хромогенных средах Синегнойная палочка образует красные колонии, окруженные зеленовато-желтоватыми зонами.
Цвет колоний: красный с зеленым окружением.
Температура и время инкубации: 35–37°C/45–51 час.
Срок годности: 12 месяцев/ 5–30°C.